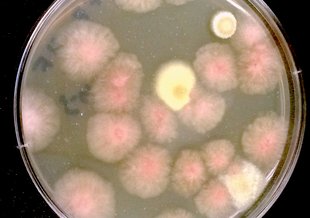
Colonies of fungi grown on the International Space Station, one of many extreme environments researchers are studying to see how microbes behave.

News & Discoveries

Newly Discovered Fossils Strengthen Proposition that World’s First Mass Extinction Engineered by Early AnimalsAug. 11, 2016

A Star’s Birth Holds Early Clues to Life-PotentialAug. 10, 2016

The Ever More Puzzling and Intriguing “Tabby’s Star”Aug. 9, 2016

Lichen Redefined as a Symbiosis of ThreeAug. 8, 2016
Mayo Clinic Studies How Life Survives Extreme EnvironmentsAug. 5, 2016

Mars Gullies Likely Not Formed by Liquid WaterAug. 4, 2016

Omani Wells May Shed Light on Martian MethaneAug. 3, 2016

Call for Applications for Baruch S. Blumberg NASA/Library of Congress Chair in Astrobiology Aug. 1, 2016

Coming to Terms with BiosignaturesJuly 28, 2016

Comparing Microbial Activity in an Arid Polar DesertJuly 27, 2016

Exoplanet Biosignatures Workshop Without WallsJuly 26, 2016

2016 Astrobiology Minority Institution Research Support (MIRS) Program FellowsJuly 25, 2016
Resources



